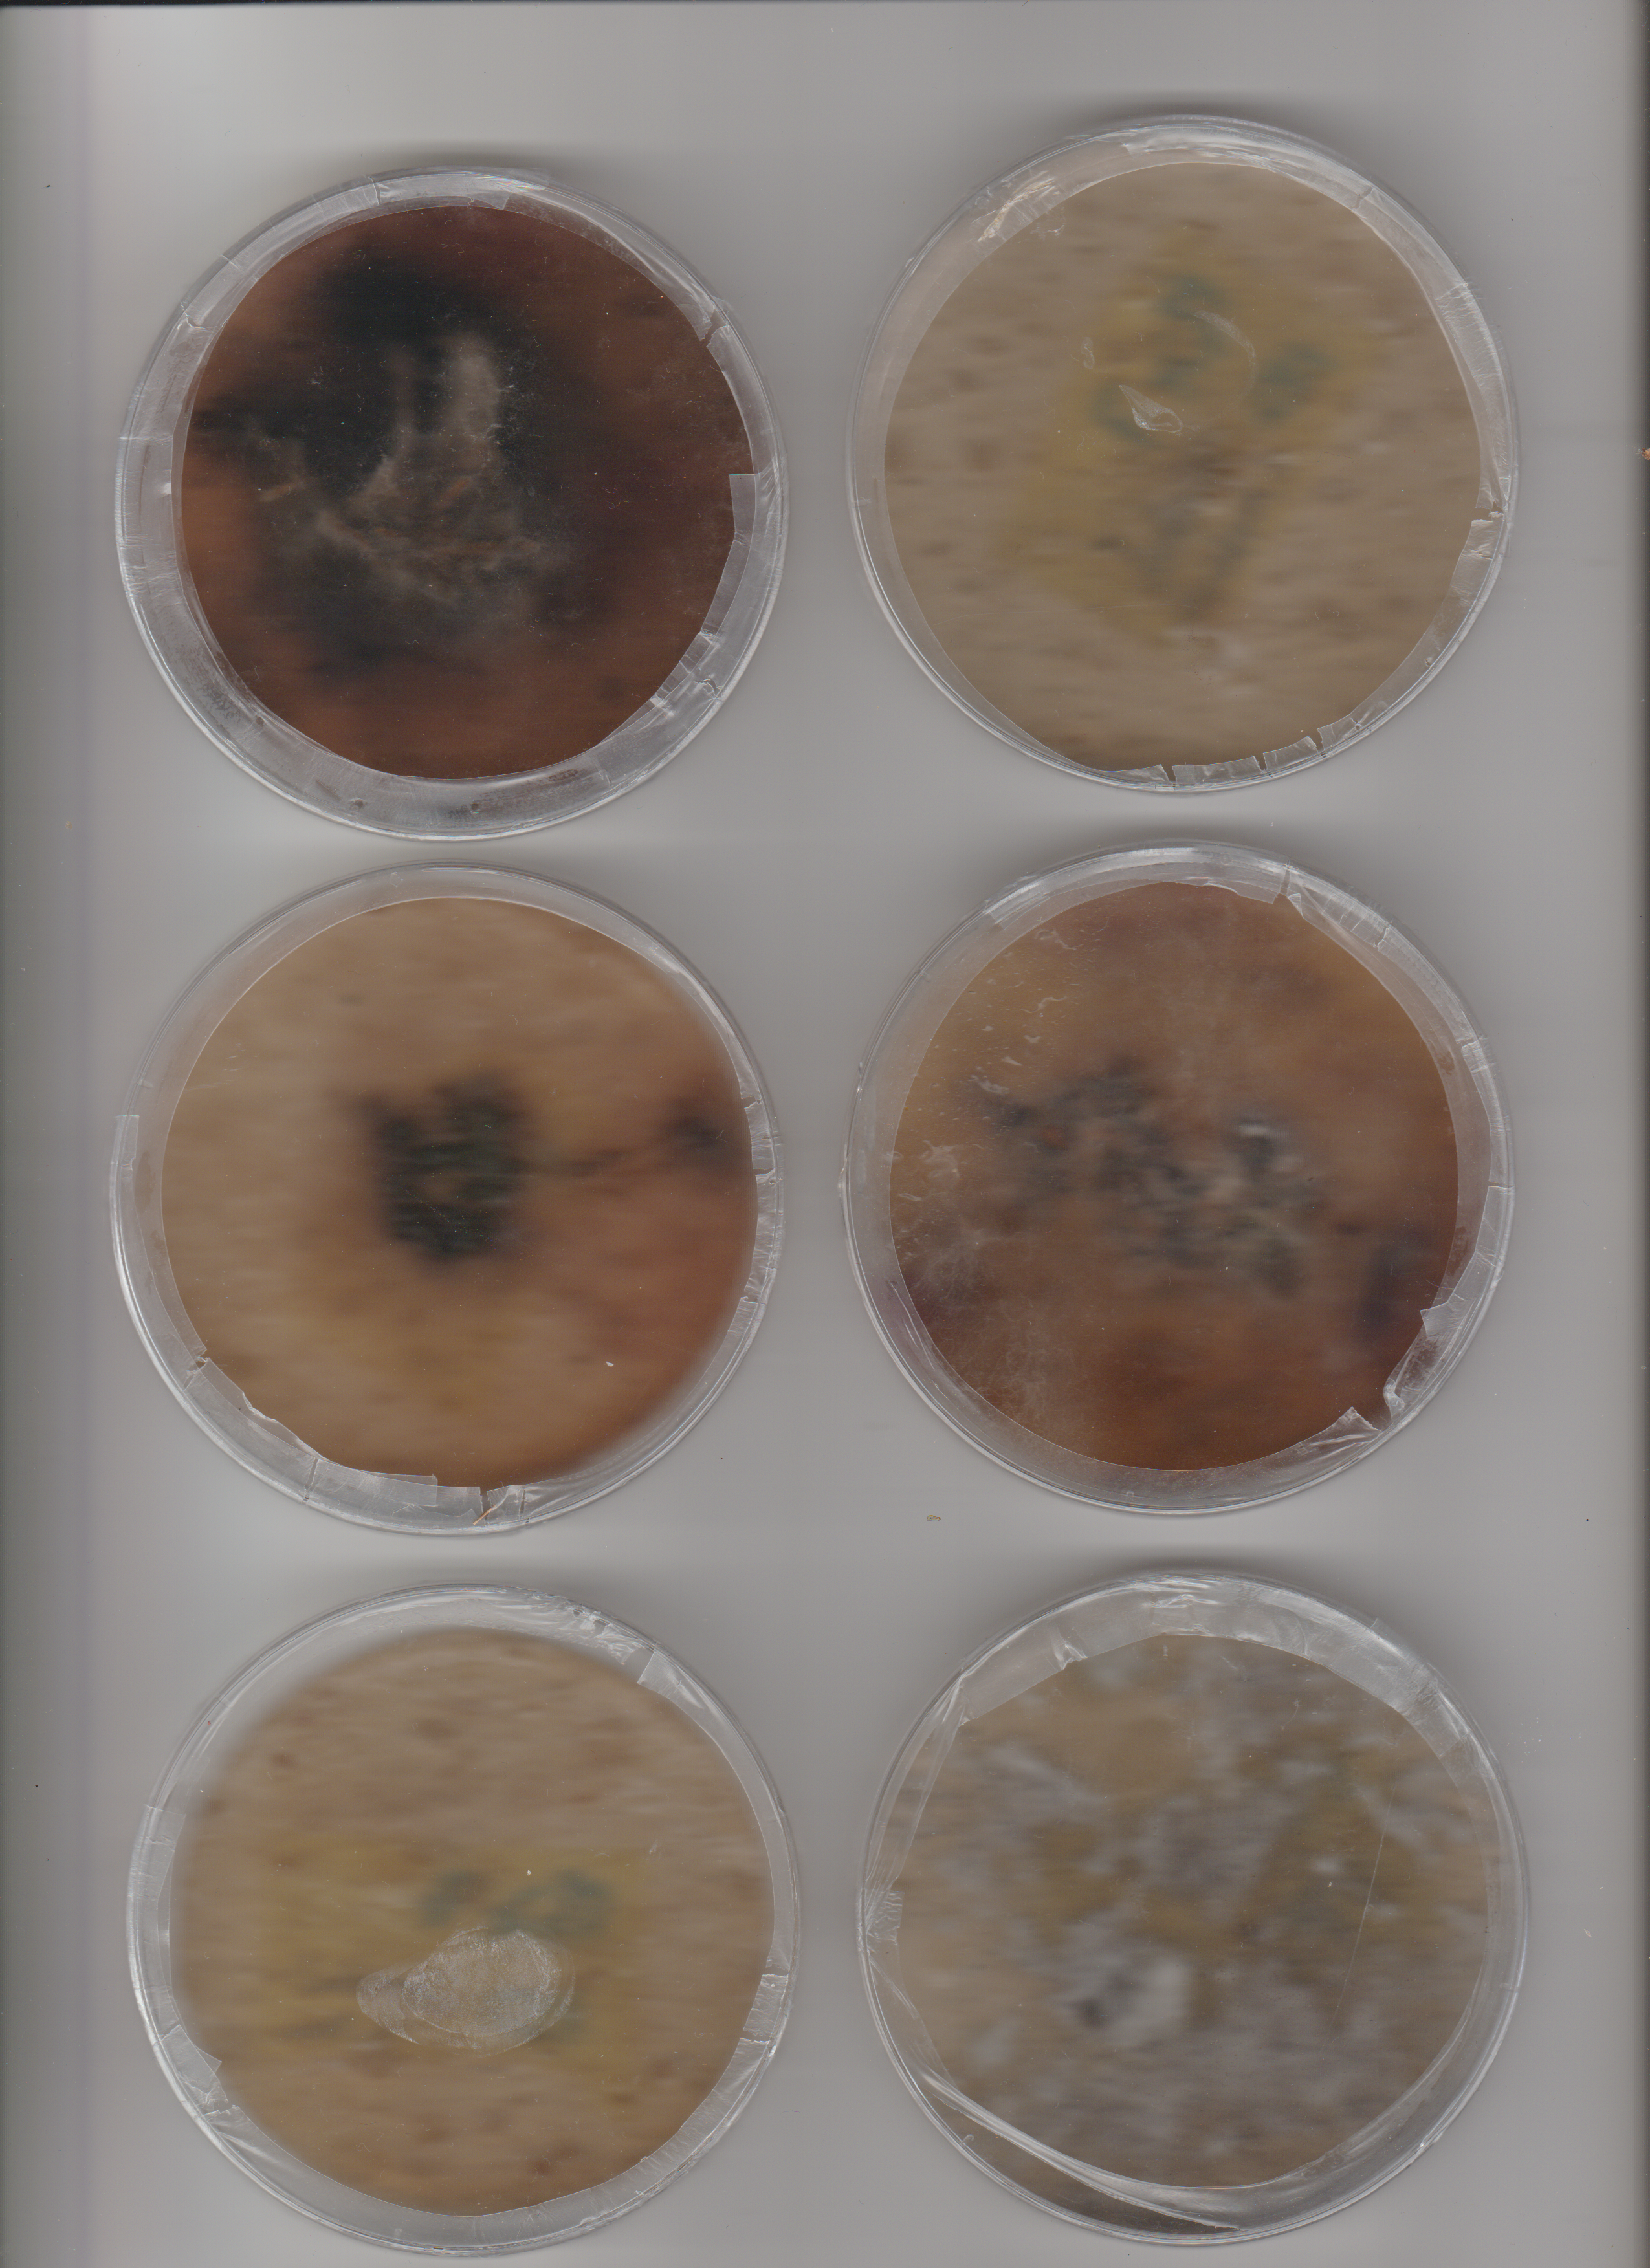
been

Critter Crisis - Think as Anima/ Fungi/ Bacteria/ Plant
Kultur ist das, was bleibt, wenn alles andere vergeht. Inmitten des ständigen Zerfalls versucht sie, Informationen zu speichern, Formen zu fixieren, Bedeutungen festzuschreiben. Sie ist der menschliche Widerstand gegen Entropie – gegen das Prinzip, nach dem jedes System früher oder später in Unordnung übergeht. Wissenschaft steht ihr dabei zur Seite, präzise und systematisch. Gemeinsam errichten sie Strukturen im Strom des Verfalls.
Doch wie lässt sich eine Welt ordnen, die sich unablässig verändert, zerfällt, wächst, stirbt und wiederkehrt? Critter Crisis ist ein Versuch, mitten in diesen biologischen Prozessen zu denken. Die ausgestellten Arbeiten bewegen sich zwischen Forschen, Sammeln, Archivieren und freien Assoziationen, an der Schnittstelle von Kunst und Wissenschaft. Das Leben wuchert, verformt sich, mutiert. Es lässt sich nicht in stabile Kategorien pressen, sondern entzieht sich immer wieder der Kontrolle.
In dieser Spannung arbeiten die Wissenschaftler:innen – sie versuchen ein lebendes System zu entwickeln, ein System, das sich weiterentwickelt, jedoch abstrahiert von seiner natürlichen Form nun neue Bedeutung in die Welt trägt.
Die Ausstellung ist kein Schaukasten fertiger Ergebnisse, sondern eine lebendige Versuchslandschaft. Zwischen Prozess und Stillstand, Struktur und Auflösung, Beobachtung und Transformation. Sie sind daher eingeladen, uns bei unserer Tätigkeit in der Temporäre Station am Hauptmarkt 29 zu begleiten. Wir bieten Ihnen die Möglichkeit, unserer Tätigkeit beizustehen, uns bei der Arbeit zu beobachten und einen Einblick in unsere Forschung zu erhalten.